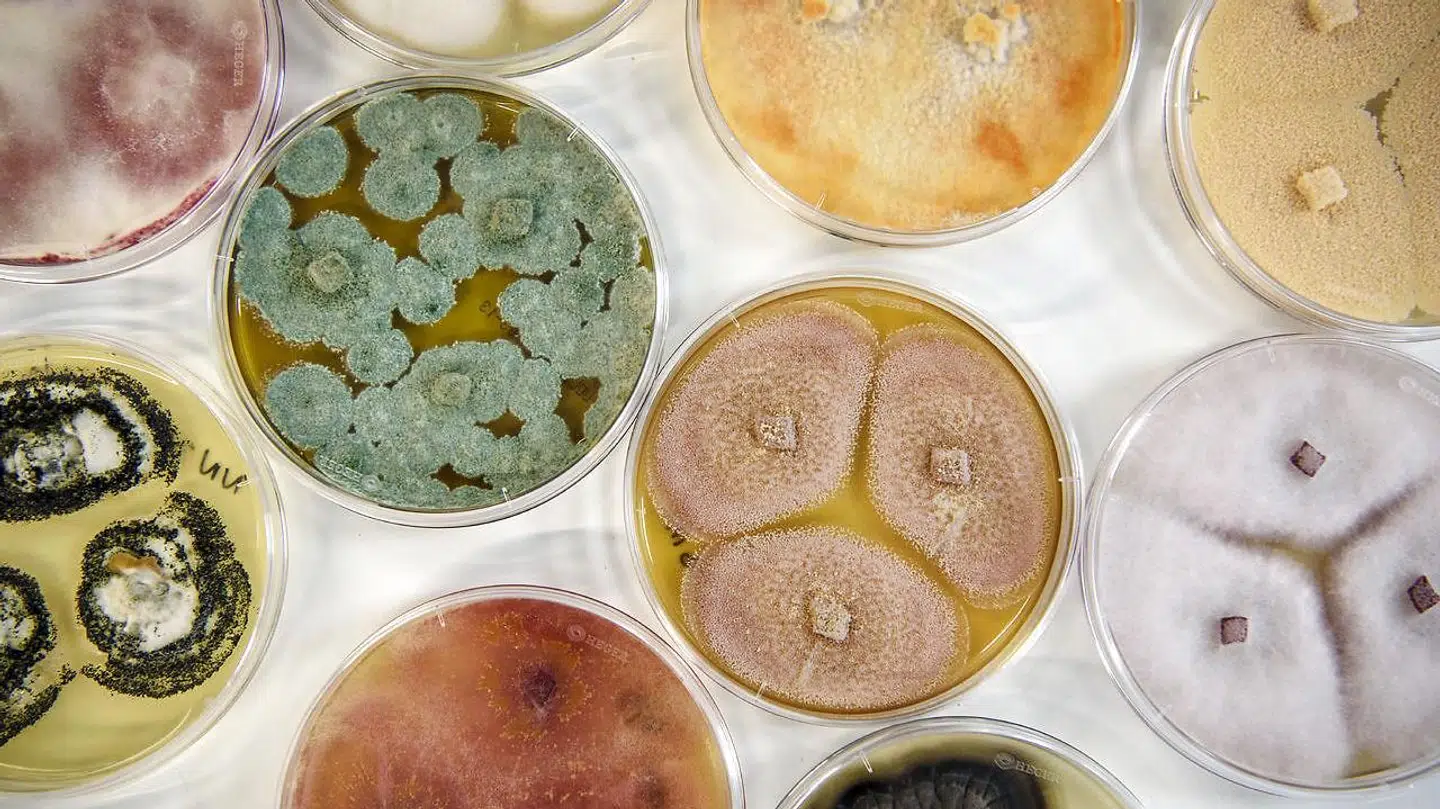
Novozymes er blandt verdens førende aktører inden for enzymer og mikroorganismer.

Udsigterne er bedre for nogle aktier end andre.
Her peger Handelsbankens senior aktiestrateg Michelle Nørgaard på tre aktier, som investorer skal passe ekstra på, eller hvor man ifølge Handelsbanken skal overveje at tage profit hjem.
Pandora
Det danske smykkeselskab er blandt de selskaber, som aktiestrategen vurderer vil møde turbulens i 2020. Hos Handelsbanken har man en forventning om, at flere og flere vil tage profit hjem - også på grund af påvirkningerne af de foranstaltninger forbrugere og myndigheder tager i forhold til coronavirus.
Selskabet har meddelt, at det har lukket 53 af dets butikker i Kina på grund af coronavirussen, hvilket svarer til en tredjedel af dets butikker i landet.
Læs også: Han har valgt at shorte Tesla
Det kinesiske marked spiller en rolle for Pandoras indtjening idet selskabet henter omkring 10% af deres omsætning på det kinesiske marked. Derfor er der ingen tvivl om, at lukningen af så mange butikker vil have en negativ indtjeningspåvirkning. Vi har dog på nuværende tidspunkt ikke fået nogen konkrete meldinger fra Pandora om hvilken effekt coronavirussen indtil videre har haft, vurderer hun.
»Selskabet har således givet udtryk for, at det endnu er for tidligt at udtale sig om,« udtaler Michelle Nørgaard og fortsætter:
»Overordnet set venter vi dog, at indtjeningen formentlig vil være under pres i 1. halvår 2020 som følge af, at forebyggende foranstaltninger vil ramme butikkernes omsætning.«
Hun mener samtidig, at Pandoras nye topchef, Alexander Lacik, flere gange har understreget, at 2020 vil blive et år med en række udfordringer i forbindelse med implementeringen af selskabets strategi ved navn 'Programme Now 2020'.

Han har flere gange udtalt, at ændringerne vil tage op mod til to år at gennemføre, og at der kan meget vel blive et eller flere blive tilbageslag, og det synes aktiemarkedet ikke at tillægge nok betydning, mener aktiestrategen.
»Vi tror i og for sig på at det kan lade sige gøre at vende Pandoras udvikling til positiv, men aktien er løbet i forvejen og vi tror der kommer et bedre tidspunkt at købe sig ind i aktien,« udtaler Michelle Nørgaard.
Novozymes
Novozymes kom ud med et relativt anstændigt regnskab for 4. kvartal 2019, vurderer Michelle Nørgaard. Men dykker man ned i den danske enzymgigants forskellige divisioner, vækker især landbrug- og foderdivisionen bekymring hos aktiestrategen.
»Landbrug- og foderdivisionen skuffede markant med en negativ organisk vækst på 9 procent i 4. kvartal 2019. Den skuffende udvikling var drevet af vejrrelaterede udfordringer og af økonomisk trængte amerikanske landmænd,« udtaler Michelle Nørgaard.

Derudover offentliggjorde Novozymes deres guidance for 2020. Novozymes venter således en organisk salgsvækst på 1-5% for 2020. Det brede guidance interval afspejler den usikkerhed, som vi har set, i forhold til markedsrelaterede udfordringer, forklarer hun.
I 2019 var de markedsrelaterede udfordringer netop årsagen til, at Novozymes så sig nødsaget til at nedjustere deres helårsforventninger ad flere omgange.
Novozymes’ anden store division vaskemiddeldivisionen - er ligeledes udfordret, vurderer hun.
»Således har de større vaskemiddelproducenter øget deres omkostningsfokus, hvilket betyder, at de ikke bruger nær så mange enzymer i deres vaskemiddelprodukter. Det resultere i, at efterspørgslen på Novozymes’ enzymprodukter vil falde,« vurderer aktiestrategen.
»Det er dog noget vi har set igennem en længere periode, men det bekymrende er, at der endnu ikke er nogen begyndende bedringstegn,« udtaler Michelle Nørgaard.
Foruden et øget omkostningsfokus blandt vaskemiddelproducenterne, rammes vaskemiddeldivisionen af de amerikanske forbrugeres forbrugsvaner. Således har de amerikanske forbrugere en tendens til at købe langt billigere vaskemiddelprodukter.
De billigere vaskemiddelprodukter indeholder ikke nær så mange enzymer som de produkter, der koster lidt mere. Det vil i sidste ende ramme efterspørgslen på Novozymes’ enzymer.
Der er med andre ord nogle ting, der giver rynker i panden, lyder det fra Handelsbanken.
Læs også: Chefporteføljeforvalter: Derfor skal du have udbytteaktier
»Når vi sammenholder ovenstående udfordringer med, at Novozymes handler med P/E-værdi på over 30 for 2020, så er der ikke råderum til fejltagelser eller skuffelser. Kombinationen af en anstrengt prisfastsættelse samt en høj risiko for, at Novozymes’ toplinjevækst vil være under pres i 2020, gør at vi finder kurspotentialet begrænset,« udtaler aktiestrategen.
Simcorp
Simcorp rapporterede i begyndelsen af februar et anstændigt regnskab for 4. kvartal 2019.
Markedet reagerede dog efterfølgende negativt eftersom selskabets guidance for 2020 var lavere end ventet.
Til trods for at Simcorp-aktien har været en smule under pres i kølvandet på regnskabet, så synes vi fortsat ikke, at der er tale om et godt opkøbstidspunkt – snarere tværtimod, påpeger aktiestrategen.
Læs også: Investor frygter den næste nedtur: Sådan beskytter han sig
»Det skyldes, at vi ikke kan udelukke, at Simcorp i de kommende 12 måneder vil rapportere en række svage kvartalsregnskaber. Det frygter vi er en reel risiko,« udtaler hun.
Hos Handelsbanken har man en forventning om, at fordelingen af markedets samlede markedsordre vil blive mere balanceret.
Det er baseret på, at der er kommet flere spillere på markedet, hvilket vil resultere i en øget konkurrence.Oveni det er forventningen, at der vil ske en yderligere konsolidering hos Simcorps slutkunder.
Endelig er der en forventning om, at de historiske sæsonbestemte cyklusudsving formodentlig vil indtræde i år. Når væksten i økonomien er aftagende, vil selskaberne formentlig ikke investere så meget i IT som tidligere. Vi vurderer, at der er en stor sandsynlighed for, at trendvendingen vil begynde i år, fortæller hun.

Derfor vurderer Michelle Nørgaard, at der er en for stor risiko forbundet med aktien.
»Ikke mindst i kølvandet på den særdeles pæne kursudvikling aktien har været igennem de sidste 12 måneder, hvor aktien er steget med omkring 30%,« udtaler hun og fortsætter:
»Den stærke kursudvikling har ligeledes betydet, at Simcorp-aktien er blevet dyr. Således handler Simcorp-aktien på nuværende tidspunkt med en P/E-værdi tæt på 40. Kombinationen af dette samt en øget risiko for skuffelser i de kommende 12 måneder gør, at vi anbefaler, at man tager gevinst hjem i Simcorp, hvis man ikke allerede har gjort det.«
Læs også: 5 aktier til 2020: 'Jeg er helt vild med den aktie'
Læs også: Investeringsøkonom om Teva: Der er sket et stemningsskifte

